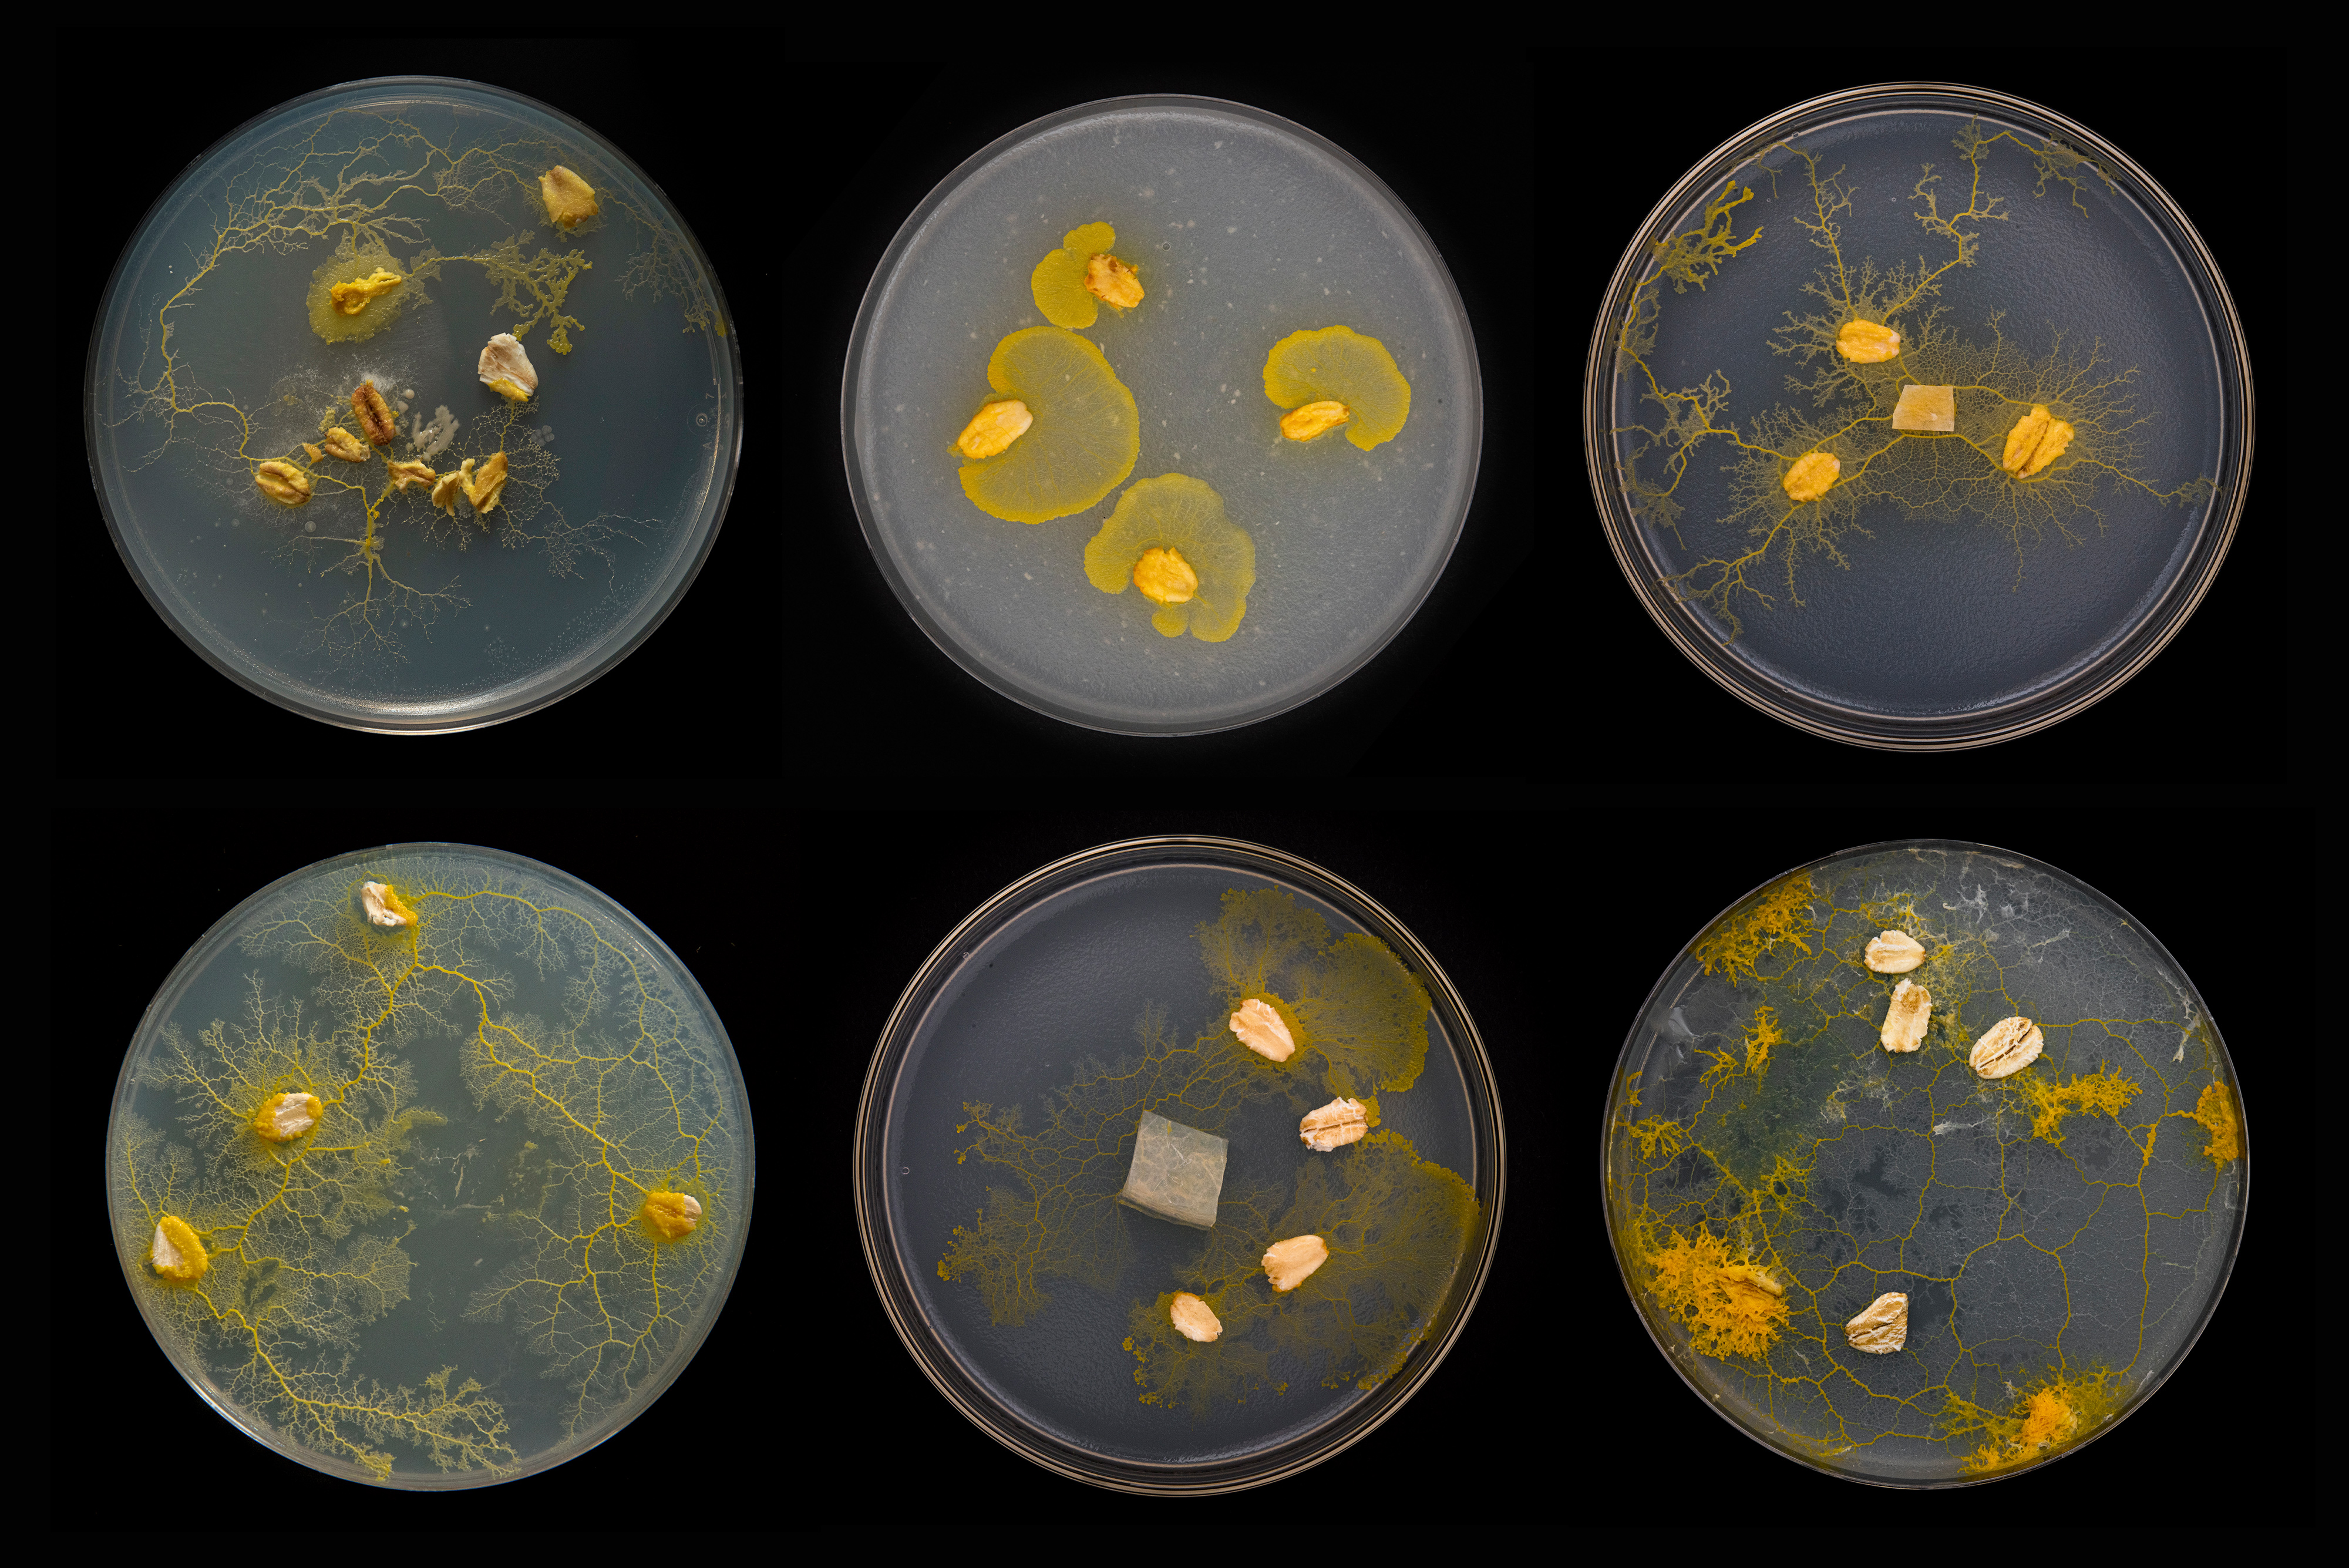

SIT(UATION) v2.0
modular inflatable seating environment for reading
modular inflatable seating environment for reading
with nick meehan
COMMISSIONED BY THE ICA, RICHMOND VA
fabricated by Pneuhaus







SIT(UATION) is a social sculpture and mutable seating system designed to situate the body as the central agent in the act of reading. The collapsability of its inflatable design allows the project to travel with relative ease, and its modularity allows collaborators to form unique configurations adapting on site for each installation, event, or moment, as desired.
05.2024

creative time CTHQ
three week residency at cthq, Creative Time’s center for art and pollitics
05.2024

the metaphysics of self immolation
book launch and collective reading for an essay in book form co-published by Façadomy and genderfail at cthq
05.2024

so close to human
a collectie poetic exercise done in collaboration with konantu (courtney smith) at cthq
The field of multisensory education has clearly demonstrated that the more of the senses we engage in the learning process, the more knowledge we retain.1 With that in mind, the act of reading would benefit from a more spatial arrangement, so then what is the spatial potential of a book2, and why are we effectively reduced to an disembodied eye3 in most of our art viewing scenarios? SIT(UATION) borrows from a critical history of seating4, and explores interspecies support systems5 using the undulating, collective intelligence of slime molds as a model through which to explore alternatives to fixed arrangements that engender a sense of experimentation and center the body in the act of reading.

- Roy, Betty J. "Matching Your Teaching to the Dyslexic’s Learning Style" 08–11, The Journal of Adventist Education Volume 53, Issue 05, 1991
- Carrión, Ulises "The New Art of Making Books" In, SECOND THOUGHTS, 6–23. Amsterdam: VOID DISTRIBUTORS, 1980.
- Diana Fuss and Joel Sanders, “An Sesthetic Headache: Notes from the Museum Bench” In, CCS Readers: Interiors, pp 64–79. Center for Curatorial Studies, Bard College, Sternberg Press, 2012.
- Opsvik, Peter "Chapter 1 why — backdrop" In, Rethinking Sitting, 12–29. New York: Norton Professional Books, 2008.
- Kropotkin, Peter. Mutual Aid: A Factor of Evolution. Courier Corporation, 2012.
The design borrows formal and functional elements from the Physarum Polycephalum, or “slime mold”—a microbial organism that forms collective bodies when food is scarce. In its aggregate form the organism is capable of sophisticated navigation, logistics and spatial memory (despite not having a brain) through a form of decentralized intelligence. This most peculiar behavior suggests the possibility that negotiating a more collective model of distribution for bodies in space might increase the potential for learning.
The social aspect of the project pulls together a mélange of influence, including radical architecture groups from the 1960s–70s, post-modern seating designers like Peter Opsvik, multisensory education, embodiment practices, and interspecies systems of mutual aid.
